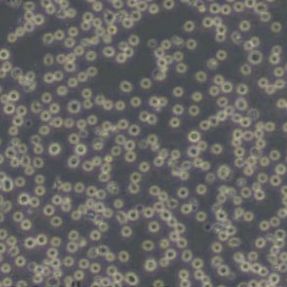
产品封面图

相关产品推荐更多 >
万千商家帮你免费找货
0 人在求购买到急需产品
- 详细信息
- 文献和实验
- 技术资料
- 品系:
/
- 细胞类型:
细胞系
- 肿瘤类型:
/
- 供应商:
优利科(上海)生命科学有限公司
- 库存:
100
- 英文名:
KG-1
- 生长状态:
悬浮细胞
- 年限:
永久
- 运输方式:
快递形式
- 器官来源:
/
- 是否是肿瘤细胞:
/
- 细胞形态:
原粒细胞
- 免疫类型:
/
- 物种来源:
人
- 相关疾病:
/
- 组织来源:
/
- 规格:
1×10⁶cells/T25培养瓶
细胞英文名称:KG-1
细胞中文名称:KG1人急性骨髓性白血病细胞(带STR鉴定)
| 名称 | KG-1 (人急性骨髓性白血病细胞) (STR鉴定正确) |
| 别称 | KG1 |
| 年龄(性别) | 男;59岁 |
| 组织来源 | 骨髓 |
| 生长特性 | 悬浮细胞 |
| 细胞形态 | 原粒细胞 |
| 背景描述 | KG-1细胞是由H·P·Koeffler和D·W·Golde建立,骨髓抽自一个59岁的患有红白血病而后又发展成急性骨髓原性白血病的男性白人。KG1细胞在形态上类似急性髓原白血病,表现为明显的多形性,骨髓母细胞和骨髓细胞占优势。KG1细胞少量是成熟的粒细胞,也有微量的巨噬细胞和嗜曙红细胞。 |
| 生长培养基 | IMDM+20% FBS+1% P/S |
| 推荐传代比例 | 1:2-1:3 |
| 推荐换液频率 | 2~3次/周 |
| 倍增时间 | ~38 hours |
| 冻存条件 | 冻存液:55% 基础培养基+40%FBS+5%DMSO温度:液氮 |
| 培养条件 | 气相:空气,95%;CO2,5%温度:37℃ |
| 抗原表达情况 | HLA A30, A31, B35, Cw4 |
| 基因表达情况 | HLA DR |
| 保藏机构 | ATCC; CCL-246 ATCC; CRL-8031 BCRC; 60158 BCRJ; 0132 DSMZ; ACC-14 ECACC; 86111306 |



STR位点信息
Amelogenin:X,Y;CSF1PO:7;D13S317:11,12;D16S539:10,11;D18S51:10.2,18;D21S11:28,29;D3S1358:15,16;D5S818:13;D7S820:8,10;D8S1179:13,14;FGA:22;PentaD:8,9;PentaE:7,13;TH01:7,8;TPOX:7,9;vWA:14,19
1、 细胞传代:
1)细胞生长至覆盖培养瓶的 80%面积时,弃 25cm2 培养瓶中的培养液,用 PBS 清洗细胞一次;
2)添加 0.25%胰蛋白酶消化液约 1ml 至培养瓶中,倒置显微镜下观察,待细胞回缩变圆后加入 5ml 完全培养
液终止消化,再轻轻吹打细胞使之脱落,然后将悬液转移至 15ml 离心管中, 1000rpm 离心 5min;
3)弃上清,沉淀细胞用 1-2ml 完全培养基重悬,然后按 1:2 比例进行分瓶传代,最后放入 37℃, 5%CO2 细胞
培养箱中培养;
2、 细胞冻存:
1)细胞生长至覆盖培养瓶的 80%面积时,弃 25cm2 培养瓶中的培养液,用 PBS 清洗细胞一次;
2)添加 0.25%胰蛋白酶消化液约 1ml 至培养瓶中,倒置显微镜下观察,待细胞回缩变圆后加入完全培养液终
止消化,轻轻吹打细胞使之脱落,然后将悬液转移至 15ml 离心管中, 1000rpm 离心 5min;
3)用适量的冻存液(FBS: DMSO=9 : 1)重悬细胞,并放置于冻存管中;
4)先将细胞冻存管放置于-20℃ 1.5h,然后将其移入-80℃过夜, 24h 后转入液氮中进行长期保存。使用程序
降温盒可直接放入-80℃。
3、细胞复苏:
1)从液氮中取出细胞冻存管(注意:佩戴防爆管面具),快速将其置入 37℃水浴中解冻,直至冻存管中无结
晶,然后用 75%的酒精擦拭冻存管外壁;
2)将冻存管中的细胞移至含 6ml 完全培养基的 15ml 离心管中, 1000rpm 离心 5min;
3)弃上清,沉淀用 6ml 完全培养基重悬,接种 25cm2 培养瓶,于 37℃, 5%CO2 细胞培养箱中培养


KG1人急性骨髓性白血病细胞(带STR鉴定)收到后处理
细胞在培养瓶中培养至良好状态后灌满完全培养液并封好瓶口是细胞运输的最好办法。收到细胞回到自己的实验室后,先打开外包装,用75%酒精喷洒整个瓶消毒后放到超净台内,严格无菌操作。镜下观察:未超过80%汇合度时,可将瓶装的完全培养液移入废液缸中,悬浮细胞需离心处理,加入6ml新鲜完全培养基,放入37℃、5%CO2孵箱培养;超过80%汇合度时,根据情况传代或者冻存,具体操作见细胞培养步骤说明书。
风险提示:丁香通仅作为第三方平台,为商家信息发布提供平台空间。用户咨询产品时请注意保护个人信息及财产安全,合理判断,谨慎选购商品,商家和用户对交易行为负责。对于医疗器械类产品,请先查证核实企业经营资质和医疗器械产品注册证情况。
文献和实验据统计约 30% 细胞系被交叉污染或错误辨识,因使用了交叉污染或错误辨识的细胞而导致研究结论错误、结果不可重复、临床细胞治疗灾难性后果……,这浪费大量时间、精力和金钱。Everything was going along fine until they discovered their HeLa cell line expressed Y chromosome markers因此近年 NIH、ATCC、Nature 和 Science 等对此多次发出呼吁,要求研究者对细胞进行鉴定。STR 基因
按FAB形态学分类,可将急性淋巴细胞白血病分为三种亚型: 1.L1型 以小细胞为主,核染色较粗,每例结构一致。核型规则呈圆型,偶有凹陷或折叠,核仁小而不清楚或不见。胞浆少,轻度或中度嗜碱性,胞浆有空泡不定。 2.L2型 以大细胞为主,混有一定数量的小细胞,大小不等明显。核染色质疏松,每例结构不一致。核形不规则,凹陷和折叠常见。核仁清楚,一个或多个,胞浆量不定常较多,浆深浅不一,有的深染,浆液可有空泡。医学教育网搜|集整理 3.L3型 以大细胞为主,大小较一致。核
急性混合细胞白血病依白血病细胞来源及表达不同分两种类型: 1.双表型:在混合细胞白血病中,确定有大于或等于10%的恶变细胞,既有淋巴细胞系,又有髓细胞系特性。 2.双系型:也可命名为双克隆型(同时有两种或多种分别表达髓系或不同淋巴系标记的白血病细胞)。检验包括细胞形态学(Auer小体)、细胞化学(包括免疫细胞化学及超微结构)、单克隆抗体医学教育|网搜集整理、E玫瑰花结、SmIg、C1q、遗传及分子生物学。依据以上多方面检测,进行综合判断,才能诊断本病。大多数病人有t